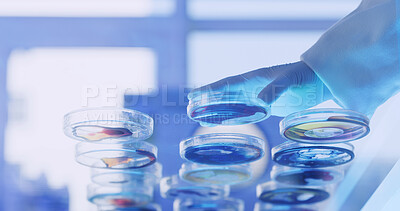
Buy stock photo Medical, hand or person in lab with petri dish, biotechnology or liquid test for vaccine development. Science, below or expert in clinic with samples, research or analysis in pharmaceutical study.

Stock Photo - Medical, hand or person in lab with petri dish, biotechnology or liquid test for vaccine development. Science, dna exam or expert in clinic with samples, research or analysis in pharmaceutical study.
Medical, hand or person in lab with petri dish, biotechnology or liquid test for vaccine development. Science, below or expert in clinic with samples, research or analysis in pharmaceutical study. - Stock Photo
Stock photo ID: 3305636
Medical, hand or person in lab with petri dish, biotechnology or liquid test for vaccine development. Science, dna exam or expert in clinic with samples, research or analysis in pharmaceutical study.
Stock Photo Keywords:
clinic lab analysis test research samples pharmaceutical expert vaccine sample biotechnology below development science study person medical technology
How do you plan to use this image?
Choose Size and Download